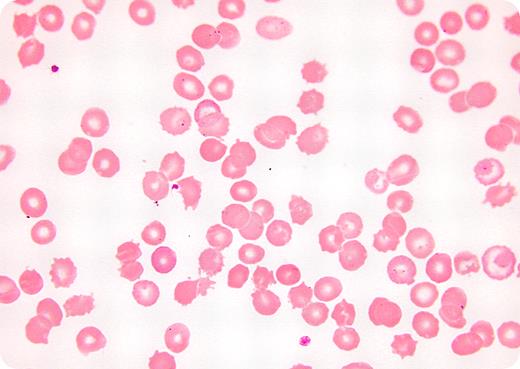
54-year-old man was seen in the emergency room with abdominal discomfort and peripheral edema. His referring physician affirmed a prior history of alcoholism, accompanied by mild anemia and target cells on his peripheral smear. When examined in the emergency room, he had jaundice, ascites, lower extremity edema, a slightly enlarged liver, and a moderately enlarged firm spleen. Stool was hemoccult negative. / Laboratory tests revealed marked anemia (hemoglobin 68 g/L) and moderate thrombocytopenia. The reticulocyte count was elevated at 7.5%. Peripheral smear (shown) had red cells with numerous spicules irregularly distributed over the membrane surfaces. Total bilirubin was markedly elevated with an increase in indirect bilirubin. Haptoglobin was very low and the Coombs test was negative. / A history of alcoholism and liver disease combined with current findings of enlarged spleen, hemolytic anemia, and a peripheral blood smear showing spiculated red cells are consistent with spur cell anemia. Spur cells have increased membrane cholesterol, increased cholesterol-to-phospholipid ratio, and membrane rigidity. Normal red cells may acquire these features after transfusion into a patient with spur cell anemia and undergo similar changes after incubation in vitro with patients' serum or with lipid mixtures containing a high cholesterol-to-phospholipid ratio. This disorder heralds rapid clinical deterioration due to progressive liver failure. Splenectomy may improve the hemolysis by eliminating the site of sequestration of spur cells, but it carries a high risk of complications and does not improve the underlying liver disease. Liver transplantation has been reported to reverse the disease process and eliminate the spur cells.

54-year-old man was seen in the emergency room with abdominal discomfort and peripheral edema. His referring physician affirmed a prior history of alcoholism, accompanied by mild anemia and target cells on his peripheral smear. When examined in the emergency room, he had jaundice, ascites, lower extremity edema, a slightly enlarged liver, and a moderately enlarged firm spleen. Stool was hemoccult negative.
Laboratory tests revealed marked anemia (hemoglobin 68 g/L) and moderate thrombocytopenia. The reticulocyte count was elevated at 7.5%. Peripheral smear (shown) had red cells with numerous spicules irregularly distributed over the membrane surfaces. Total bilirubin was markedly elevated with an increase in indirect bilirubin. Haptoglobin was very low and the Coombs test was negative.
A history of alcoholism and liver disease combined with current findings of enlarged spleen, hemolytic anemia, and a peripheral blood smear showing spiculated red cells are consistent with spur cell anemia. Spur cells have increased membrane cholesterol, increased cholesterol-to-phospholipid ratio, and membrane rigidity. Normal red cells may acquire these features after transfusion into a patient with spur cell anemia and undergo similar changes after incubation in vitro with patients' serum or with lipid mixtures containing a high cholesterol-to-phospholipid ratio. This disorder heralds rapid clinical deterioration due to progressive liver failure. Splenectomy may improve the hemolysis by eliminating the site of sequestration of spur cells, but it carries a high risk of complications and does not improve the underlying liver disease. Liver transplantation has been reported to reverse the disease process and eliminate the spur cells.
54-year-old man was seen in the emergency room with abdominal discomfort and peripheral edema. His referring physician affirmed a prior history of alcoholism, accompanied by mild anemia and target cells on his peripheral smear. When examined in the emergency room, he had jaundice, ascites, lower extremity edema, a slightly enlarged liver, and a moderately enlarged firm spleen. Stool was hemoccult negative.
Laboratory tests revealed marked anemia (hemoglobin 68 g/L) and moderate thrombocytopenia. The reticulocyte count was elevated at 7.5%. Peripheral smear (shown) had red cells with numerous spicules irregularly distributed over the membrane surfaces. Total bilirubin was markedly elevated with an increase in indirect bilirubin. Haptoglobin was very low and the Coombs test was negative.
A history of alcoholism and liver disease combined with current findings of enlarged spleen, hemolytic anemia, and a peripheral blood smear showing spiculated red cells are consistent with spur cell anemia. Spur cells have increased membrane cholesterol, increased cholesterol-to-phospholipid ratio, and membrane rigidity. Normal red cells may acquire these features after transfusion into a patient with spur cell anemia and undergo similar changes after incubation in vitro with patients' serum or with lipid mixtures containing a high cholesterol-to-phospholipid ratio. This disorder heralds rapid clinical deterioration due to progressive liver failure. Splenectomy may improve the hemolysis by eliminating the site of sequestration of spur cells, but it carries a high risk of complications and does not improve the underlying liver disease. Liver transplantation has been reported to reverse the disease process and eliminate the spur cells.
Many Blood Work images are provided by the ASH IMAGE BANK, a reference and teaching tool that is continually updated with new atlas images and images of case studies. For more information or to contribute to the Image Bank, visit www.ashimagebank.org.
This feature is available to Subscribers Only
Sign In or Create an Account Close Modal